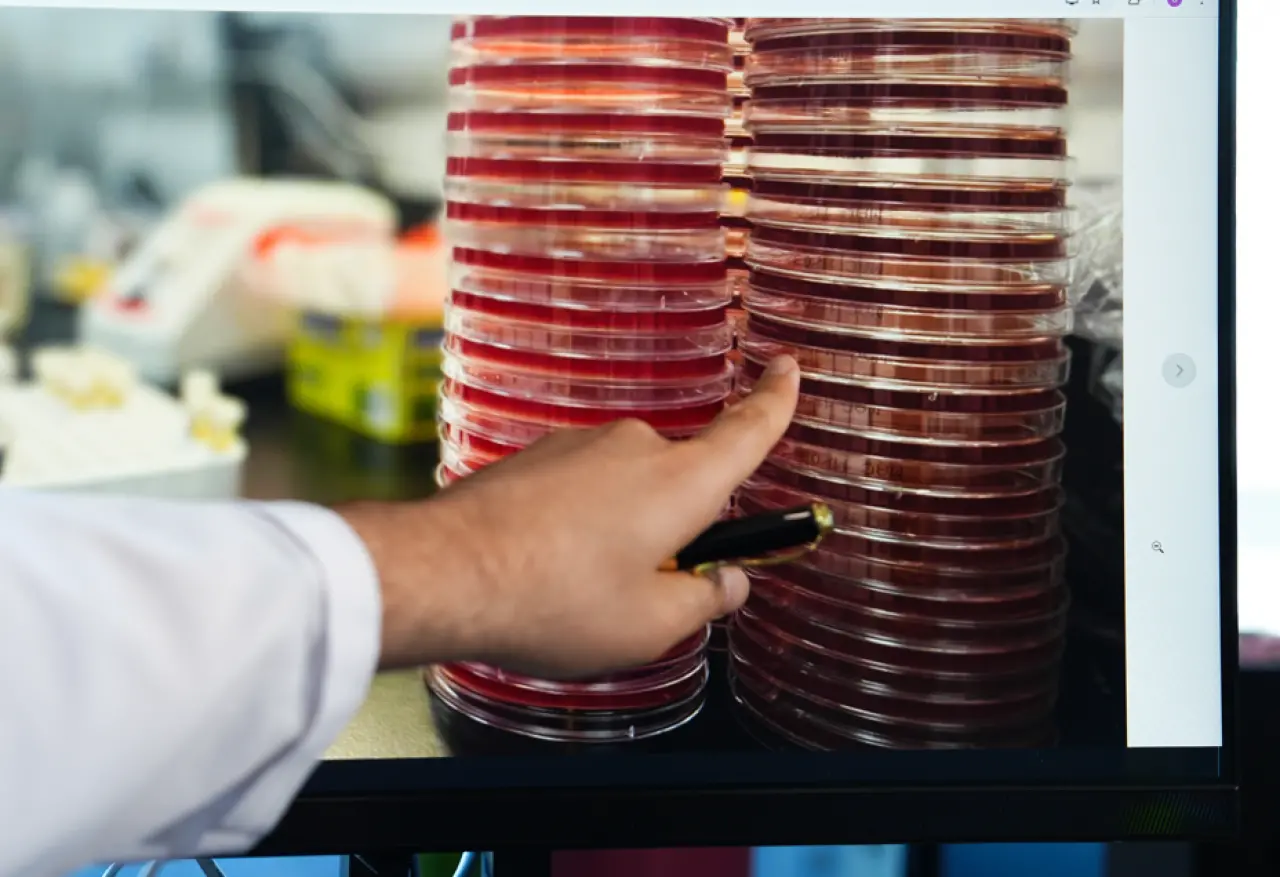

Göz, yalnızca görme işleviyle değil, üzerinde barındırdığı mikroorganizmalarla da bilim dünyasının ilgi odağı haline geliyor. Göz yüzeyinde yaşayan bakteri, mantar ve virüslerden oluşan göz mikrobiyomu, şimdi ilk kez uzay ortamına taşındı. Bu öncü araştırmada Türkiye’den Medipol Acıbadem Bölge Hastanesi Göz Hastalıkları Uzmanı Dr. Öğr. Üyesi Uğur Tunç da görev aldı.
Gözde yaşayan görünmeyen canlılar
Uzun süre steril kabul edilen göz dokusu, gelişen biyoinformatik analizler sayesinde artık mikroorganizmaların da yaşadığı bir ekosistem olarak tanımlanıyor. Dr. Tunç, “Yeni nesil DNA analizleriyle göz yüzeyinde mikroorganizmaların varlığını tespit edebiliyoruz. Bu canlıların dengesi bozulduğunda ise kuru göz, alerjik konjonktivit ya da üveit gibi hastalıklarla bağlantılı sorunlar ortaya çıkabiliyor” dedi.

Göz mikrobiyomu uzaya taşındı
Mart 2025’te SpaceX’in FALCON-9 roketiyle gerçekleştirilen FRAM-2 görevinde göz mikrobiyomu ilk kez uzay ortamında incelendi. Polar yörüngede beş gün süren yolculuk boyunca aynı kişilerden alınan örnekler hem Dünya’da hem de uzayda saklanarak karşılaştırmalı analiz için kullanıldı. Projede Suudi Arabistan, Belçika, Malta ve Florida’dan bilim insanları görev aldı. Dr. Tunç, göz mikrobiyomu örneklerinin toplanması ve analiz protokollerinin oluşturulmasında aktif rol üstlendi.
Uzayda mikroorganizmaların davranışı ne anlatıyor?
Yerçekimi, radyasyon ve atmosfer koşullarının uzayda mikroorganizmaların DNA ve protein yapıları üzerinde değişimlere yol açabileceği düşünülüyor. Dr. Tunç, bu araştırmaların gelecekte uzayda uzun süre kalacak insanların sağlık sorunlarını çözmede kritik rol oynayabileceğini vurguladı:
“Mikroorganizmalar, DNA ve protein sentezi açısından insan fizyolojisine benzer özellikler taşıyor. Bu nedenle uzayda mikrobiyom davranışlarını anlamak, insan sağlığına dair ipuçları sunuyor. 50-60 yıl sonra uzayda yaşam kaçınılmaz olduğunda, göz mikrobiyomu da çözmemiz gereken konular arasında olacak.”